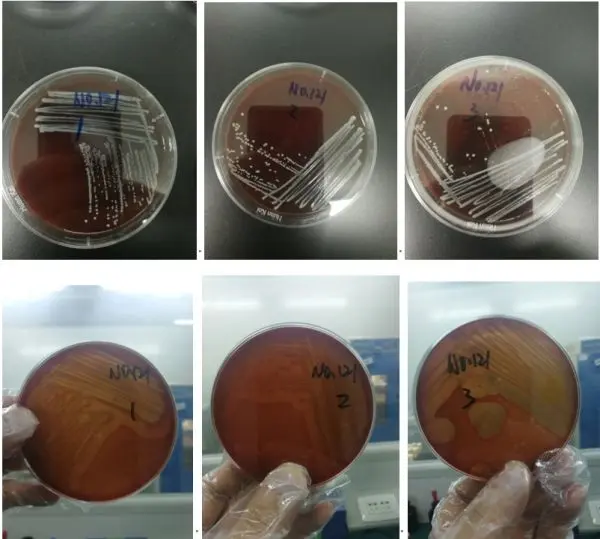
血平板(溶血观察) 血平板(溶血观察)

[实例分享]食品中金黄色葡萄球菌(定量)检测的能力验证
发布时间:2025-12-30 浏览次数:3095
一、能力实验的目的
开展能力验证试验是检验实验室检测能力和提高检测水平的重要手段。利用实验室间的比对,对实验室的校准或检验工作进行判定。目的是为了实现确定某个实验室进行某些特定检测或测量能力,以及监控实验室的持续能力。
二、能力验证步骤
1、前期做好充足的准备工作,根据国家标准,尽可能制定一个检验检测的方案,以便保证结果的准确性。
2、样品来源:2瓶不同的真空西林瓶装白色冻干粉末样品
3、样品处理
样品储存:-15℃以下冷冻保存
样品活化步骤(建议):-20℃~ 4℃(30min),然后室温(30min),接着样品再水化(尽量减少大范围温度变化对待测样品的影响)。
样品再水化:一般能力验证样品以国体粉末形式发放,以液体(CFU/mL)形式出报告。样品再水化前一定要认真、仔细阅读作业指导书,无特殊规定,本次水化后的样品40mL为待测原液。
4、方法选择国标第二法

5、B-P平板计数(20 CFU ~200 CFU)

(1)1号样品:37℃,培养48h
100稀释(接种量0.3mL,0.3mL,0.4mL)

1000倍稀释(接种量0.3mL,0.3mL,0.4mL)

(2)2号样品:37℃,培养48h
10稀释(接种量0.3mL,0.3mL,0.4mL)

100稀释(接种量0.3mL,0.3mL,0.4mL)

平板涂布不是很好,有少部分菌落跑到了平板边缘处,对于计数会有些影响。大家在该操作过程中涂布棒尽量不要接触平板边缘。
注意事项:
a.Baird-Parker琼脂平板制作:尽量在试验前一天制作好,当天制作平板得出的结果与之相差较大,原因可能是平板涂布时没有完全干燥导致的。
b.梯度稀释(25mL+225mL):是关键步骤,必须尽可能地减少误差(新手建议涡旋混匀,涡旋时间不宜过长,长时间离心力等作用下,微生物细胞可能死亡)。
c.涂布:尽可能涂布均匀,不要接触平板边缘,避免菌落叠在一起,而导致无法计数。
6、血平板(溶血观察)

(1)1号样品溶血情况(正反面)挑取平板5个菌落进行试验(只列出前三个菌落结果)

(2)2号样品溶血情况(正反面,只列出前三个菌落结果)
7、血浆凝固酶试验

(2)血浆凝固酶试验
1号样品:

2号样品:

7、镜检
(1)1号样品

(2)2号样品

8、 能力验证结果

来源:环凯转载于食品微生物检测公众号。
提醒:文章、视频、图片等所有内容,仅用于学习交流,若有侵权内容及其他涉法内容,请及时联系删除或修改,特此声明!
